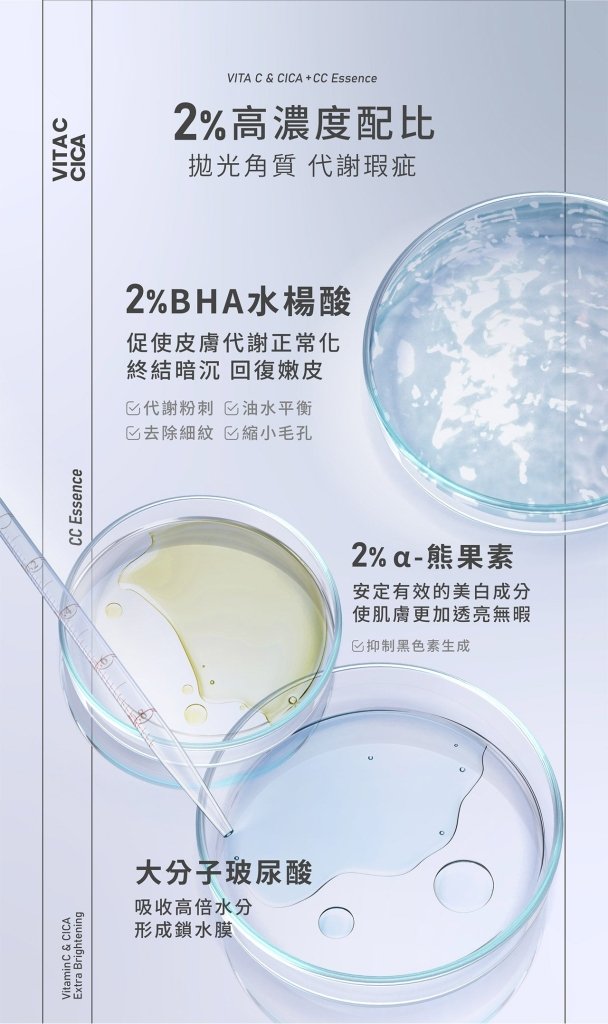
未來美 超級雙C美白淡斑精華 - 30ml

品牌起源
品牌起源
- 台灣
產品效果
產品效果
- Hydrating
- Illuminating
- Uneven skin tone
- Whitening
- Anti-dark spot
- Anti-redness
- Brightening
膚質 & 特性
膚質 & 特性
- Dry
- All skin types
未來美 超級雙C美白淡斑精華 - 30ml
未來美 超級雙C美白淡斑精華 - 30ml
Vendor: 未來美 | Mirae
 輕鬆上手,綻放光澤
輕鬆上手,綻放光澤
有現貨
- 不只白,更亮出年輕感!Vit-C×CICA雙C有效吸黑,改善棕/灰/紅/黃,層層擊破4大肌膚色偏問題,打造完美無瑕的冷白瓷肌!
- 濃縮精露質地,一拍就滲透,清爽不油膩
- 2%高濃度配比:2%BHA水楊酸、2%α-熊果素、大分子玻尿酸
- 訂單金額滿 $60,即享免運
- 配送至美國本土48州
- 支持在地好產品
-
預計送達時間: Dec 17 - Dec 21
Couldn't load pickup availability
免責聲明
商品說明僅供參考
我們致力於提供正確且即時的商品資訊,包括營養成分、過敏原、加州 Proposition 65 警語及原產地等資料,內容多依據商品包裝與第三方來源整理。然而,我們無法保證資訊的絕對正確性、完整性或即時性,所提供內容僅供一般參考使用。
商品實際成分與包裝資訊可能會與網站所顯示內容有所差異,建議您以實際產品包裝、標示與說明書為準,以獲得最準確的資訊。如有特定疑問或需進一步了解,我們建議您直接聯繫商品製造商查詢。
加州 Proposition 65 警語
本網站販售的部分商品可能含有被加州政府認定會導致癌症、出生缺陷或其他生殖危害的化學物質。
依據《加州第65號提案法案》(Proposition 65)之規定,我們提供此警語,協助消費者做出知情的選擇。
更多相關資訊請參閱官方網站:www.P65Warnings.ca.gov。
注意:化妝品效果存在差異
ding-go.com 上的任何產品均不用於診斷、治療、治癒或預防任何疾病。
1. 個體結果可能有所不同:
- 請注意,使用我們的化妝品的效果因用戶而異。
- 皮膚類型、年齡、使用習慣和生活方式等因素都會影響產品的有效性。
2.個人因素:
- 每個人的皮膚特徵都是獨特的,這會影響產品的效果。
- 現有的皮膚狀況或敏感性可能會影響對某些產品成分的反應。
3.正確使用以獲得最佳效果:
- 遵守使用說明對於實現預期結果至關重要。
- 按照提供的指南定期和持續使用可最大限度地提高獲得預期結果的可能性。
4.專家諮詢:
- 我們建議在開始新的護膚方案之前先與皮膚科專家或有執照的美容師進行討論。
品牌起源
品牌起源
- 台灣
產品效果
產品效果
- Hydrating
- Illuminating
- Uneven skin tone
- Whitening
- Anti-dark spot
- Anti-redness
- Brightening
膚質 & 特性
膚質 & 特性
- Dry
- All skin types

未來美 超級雙C美白淡斑精華 - 30ml
變美專區
KIMIWA 麻油神經醯胺油 - 70g
Choose your option
Kirei de Beaute 清新香皂 - 100g
Choose your option
熊本熊薰衣草護手霜 - 23克
Choose your option
Love Liner 經典貼合睫毛膏 卡布奇諾棕色 - 6.5g
Choose your option
M&D 保濕百合花香護手護甲霜 - 35克
Choose your option
少女柔膚凝膠霜 - 55克
Choose your option
Arencia 皇家牛膝草藍年糕潔面乳 - 120g
Choose your option
Arencia 法式金盞花橘年糕潔面乳 - 120g
Choose your option
Arencia 深層水潤凝膠精華 - 50g
Choose your option
Arencia 深層水潤精華液 - 30ml
Choose your option
Arencia 綠意清新年糕潔面乳 - 120ml
Choose your option
Arencia 皇家玫瑰果凝膠精華 - 50g
Choose your option
【招牌香氛組 大送小】SABON身體磨砂膏 經典PLV - 600g + 60g
Choose your option
【補水、毛孔、光滑三件套】Arencia 年糕潔面乳隨身小樣組- 3 × 15g
Choose your option
【粉絲回購冠軍 1+1】Dr. May 美博士專業隔離高效防曬乳 - 2 x 60ml
Choose your option
【亮彩偽素顏 1+1】美博士潤色清爽防曬乳 - 2 x 40ml
Choose your option
【醫美級煥顏】專業院線PDRN新生精華 & 新生面膜2件套
Choose your option
【全效面膜包月組】8分鐘超級面膜 - 4 x 5片
Choose your option
【瑕疵肌閉眼入】Dr. May美博士B3抗痘小黑瓶 + 高效防曬乳 - 10ml + 60ml
Choose your option
【超值全功效組】Dr. May 美博士潤色清爽 + 專業隔離防曬乳 - 40 + 60ml
Choose your option
SABON 盛宴橄欖明星推薦組 - 3部曲
Choose your option
每則評論可獲得 5 點積分(10 點 = 1 美元)

【聖誕限定】Colladaily膠妍德麗膠原蛋白粉 - 7g x 15包
Choose your option

KATE 3D立體眉膏 Z BR-2 淺棕色 - 6.3g
Choose your option

Heroine Make 持久柔滑液體眼線筆 01 濃黑 - 0.4g
Choose your option

Love Liner 經典貼合睫毛膏 卡布奇諾棕色 - 6.5g
Choose your option

Love Liner 全效睫毛精華液 - 5g
Choose your option

mamicosme 口香糖 #04 草莓玫瑰 - 8 克
Choose your option

Arencia 皇家玫瑰果精華液 - 30ml
Choose your option

Arencia 深層水潤凝膠精華 - 50g
Choose your option

Arencia 綠意清新年糕潔面乳 - 120ml
Choose your option
品牌焦點
由內而外補充肌膚所需營養,打造自信光采。 無人工色素、無防腐劑,輕鬆融入日常保養。
優龍 | U-LONG
一款漂色眉膏,可柔化眉毛的自然深色調,打造更柔和的妝效。
株式会社カネボウ化粧品
蘊含四種精華成分,有效滋潤眼周肌膚。
株式会社伊勢半
斜角小刷頭易於控制,輕鬆打造流暢自然的眉妝!
msh株式会社 (msh Inc.)
早晚保養後,清潔睫毛後使用。
msh株式会社 (msh Inc.)
是一款腮紅唇彩產品,擁有如同軟糖般觸感的全新質感。
ツーウェイワールド株式会社
消減 1/3 毛孔,打造緊緻、果凍般 Q 彈的肌膚質感。
아렌시아 | Arencia
深層水潤配方: 補水的同時,維持油水平衡,即使是敏感肌也能安心使用!
아렌시아 | Arencia
經 72 小時發酵工序,每一批皆揉製超過 7,200 次,打造 Arencia 標誌性的麻糬般柔韌質地。
아렌시아 | Arencia









變美專區
Heroine Make 長高級膜型捲睫毛膏 02 棕色 - 6g
Choose your option
Heroine Make 高級薄膜 迷你睫毛膏 01 濃密 - 4.5g
Choose your option
Heroine Make 高級薄膜型 迷你睫毛膏 02 棕色 - 4.5g
Choose your option
Heroine Make 持久防水睫毛膏 02 棕色 - 6g
Choose your option
Heroine Make 超防水濃密睫毛膏 02 棕色 - 6g
Choose your option
Heroine Make 高級膜長捲睫毛膏 01 濃黑 - 6g
Choose your option
Heroine Make 持久防水睫毛膏 01 黑色 - 6g
Choose your option
Heroine Make 超防水濃密睫毛膏 01 黑 - 6g
Choose your option
【聖誕限定】Heroine Make Prime 持久亮澤液體眼線筆 01 濃黑 - 0.4g
Choose your option
Heroine Make Prime 濃稠持久型 液態眼線筆 02 棕黑色 - 0.4g
Choose your option
Heroine Make Prime 濃稠持久型 液態眼線筆 03 自然棕色 - 0.4g
Choose your option
Heroine Make Prime 液體眼線筆 Rich Keep 04 酒紅色 - 0.4g
Choose your option
mamicosme 口香糖 #01 櫻桃紅 - 8克
Choose your option
mamicosme 口香糖 #02 桃粉色 - 8克
Choose your option
mamicosme 口香糖 #03 Coral Orane - 8克
Choose your option
mamicosme 口香糖 #04 草莓玫瑰 - 8 克
Choose your option
mamicosme 軟糖高光 #01 銀月 - 8克
Choose your option
mamicosme 軟糖高光 #02 亮粉紅色 - 8克
Choose your option
mamicosme 軟糖螢光筆 #03 香檳老 - 8 克
Choose your option
熊本玫瑰潤唇膏 - 10g
Choose your option
熊本熊草莓潤唇膏 - 10克
Choose your option
熊本熊薄荷潤唇膏 - 10克
Choose your option
mamicosme 口香糖 #01 櫻桃紅 - 8克
Choose your option
mamicosme 口香糖 #02 桃粉色 - 8克
Choose your option
mamicosme 口香糖 #03 Coral Orane - 8克
Choose your option
mamicosme 口香糖 #04 草莓玫瑰 - 8 克
Choose your option
【聖誕限定】曼秀雷敦 水潤護唇膏-蜜桃金 (SPF20 PA++)
Choose your option

未來美 修護時空膠囊精華膜 - 80ml
Choose your option

未來美 雲朵泡泡潔顏慕絲 - 150ml
Choose your option

未來美 超級A醇緊緻煥白面膜 - 3片/盒
Choose your option

未來美 超級雙C美白淡斑精華 - 30ml
Choose your option

Dr. May 專業級大安瓶修護黑面膜 - 4片/盒
Choose your option

Dr. May 美博士專業隔離高效防曬乳 SPF50+PA++++(60ml)
Choose your option

Dr. May 美博士B3 PRO專業淨膚抗痘精華加強版 - 10ml
Choose your option

Dr. May 美博士潤色清爽防曬乳SPF50+ PA++++(40ml)
Choose your option
品牌焦點
雙層時空膠囊,修護力加倍!可作為「晚安面膜」或是「救急面膜」!
未來美 | Mirae
蘊含韓國3D玻尿酸,洗後水潤不乾澀!
未來美 | Mirae
獨特延長提拉帶設計,360°完美包覆任何臉型,一敷就繃!
未來美 | Mirae
不只白,更亮出年輕感!打造完美無瑕的冷白瓷肌!
未來美 | Mirae
一片大安瓶黑面膜 神經醯胺添加水光保濕++
美博士 | Dr. May
高效版防曬乳,海洋友善,戶外防水,臉和身體皆適用 !
美博士 | Dr. May
護膚黑科技「自由酚」金牌抗氧,美國期刊加持!
美博士 | Dr. May
清爽潤色不悶痘,醫美術後首選,降低致粉刺機率。
美博士 | Dr. May








寵愛自己
Kaori珊瑚保護劑 - 39克
Choose your option
M&D 牛奶狀防曬噴霧 SPF35 PA++ - 45毫升
Choose your option
M&D UV 防曬貼 SPF 25 PA+++(10 片裝)- 30 克
Choose your option
【亮彩偽素顏 1+1】美博士潤色清爽防曬乳 - 2 x 40ml
Choose your option
【粉絲回購冠軍 1+1】Dr. May 美博士專業隔離高效防曬乳 - 2 x 60ml
Choose your option
【超值全功效組】Dr. May 美博士潤色清爽 + 專業隔離防曬乳 - 40 + 60ml
Choose your option
Dr. May 美博士潤色清爽防曬乳SPF50+ PA++++(40ml)
Choose your option
Dr. May 美博士專業隔離高效防曬乳 SPF50+PA++++(60ml)
Choose your option
SABON 石榴保濕亮髮醋 - 190ml
Choose your option
SABON 低泡溫和淨化洗髮乳 以色列綠玫瑰 - 30ml
Choose your option
KIMIWA 麻油精華護髮素 - 350g
Choose your option
KIMIWA 麻油精華洗髮精 - 350g
Choose your option
玫瑰護髮乳液 - 123克
Choose your option
玫瑰護理液 - 237克
Choose your option
玫瑰洗髮 - 248克
Choose your option
SIRACA 強效洗髮精 - 600克
Choose your option
SABON 迷你淨潤洗髮乳 茉莉花語 - 50ml
Choose your option
SABON 迷你淨潤洗髮乳 以色列綠玫瑰 - 50ml
Choose your option
髮翳淨髮露 - 550g
Choose your option
SABON 低泡溫和淨化洗髮乳 以色列綠玫瑰 - 30ml
Choose your option
SABON 迷你淨潤洗髮乳 茉莉花語 - 50ml
Choose your option
SABON 迷你淨潤洗髮乳 以色列綠玫瑰 - 50ml
Choose your option
SABON 居家SPA身體磨砂膏 白茶 - 320g
Choose your option
SABON 小巧輕量身體磨砂膏 白茶 - 60g
Choose your option
KIMIWA 麻油神經醯胺油 - 70g
Choose your option
草本皂 艾草尤加利檸檬口味 - 53克
Choose your option
草本薄荷和魚腥草香皂 - 53克
Choose your option
草本薰衣草皂 - 53克
Choose your option
草本玫瑰香皂 - 53克
Choose your option
柿子單寧和茶葉KT皂 - 80克
Choose your option
水綠熊香皂 YS(2塊)- 220克
Choose your option

SABON 沐浴油 以色列綠玫瑰 - 500ml
Choose your option

SABON 小巧輕量身體磨砂膏 經典PLV - 60g
Choose your option

SABON 升級版身體磨砂膏 以色列綠玫瑰 - 600g
Choose your option

SABON 經典身體磨砂膏 玫瑰茶語 - 600g
Choose your option

SABON 極潤護手霜 橙花漫舞 - 75ml
Choose your option

SABON 沐浴油 茉莉花語 - 500ml
Choose your option

SABON 迷你護手霜 經典PLV - 30ml
Choose your option

SABON 低泡溫和淨化洗髮乳 以色列綠玫瑰 - 30ml
Choose your option
品牌焦點
清透質地,沖洗後輕盈而不油膩,蘊含營養豐富的橄欖油與荷荷芭油保濕滋潤。
סַבּוֹן | SABON
經典PLV是SABON原創的香氣,揉合廣藿香、薰衣草、香蘭三種氣息,以獨特廣藿香喚醒感官。
סַבּוֹן | SABON
新肌感! 死海鹽蘊含 21 種珍貴礦物,潔淨、淨化並補水。
סַבּוֹן | SABON
溫和按摩肌膚,有助淡化暗沉,讓肌膚更柔嫩光滑,展現細緻透亮的光采。
סַבּוֹן | SABON
乳木果油深層修護,蘆薈則為肌膚補水並舒緩不適。
סַבּוֹן | SABON
茉莉香調:清新淡雅,散發低調而高貴的氣息。
סַבּוֹן | SABON
輕盈不黏膩的質地,能瞬間保濕,並讓香氣自然綻放。
סַבּוֹן | SABON
我們的 Low Shampoo 以簡單一步帶來全新的溫和潔髮方式。
סַבּוֹן | SABON








護膚保養
Arencia 深層水潤精華液 - 30ml
Choose your option
Arencia 大米珍珠亮采精華液 - 30ml
Choose your option
KIMIWA 胎盤精華 - 56g
Choose your option
Dawn Loofah 天然維生素C精華液 DL - 150毫升
Choose your option
SIRACA精華液 - 30毫升
Choose your option
未來美 超級雙C美白淡斑精華 - 30ml
Choose your option
未來美 超級A醇精華升級版 - 30ml
Choose your option
未來美 專業院線PDRN外泌體新生精華 - 15ml + 15ml
Choose your option
Arencia 大米珍珠亮采凝膠精華 - 50g
Choose your option
Arencia 皇家玫瑰果凝膠精華 - 50g
Choose your option
Dr. May 美博士B3 PRO專業淨膚抗痘精華加強版 - 10ml
Choose your option
Dr. May 美博士智慧型杏仁酸煥膚精華 - 10ml
Choose your option
得生製藥 燕窩晶透生物纖維面膜 - 3片/盒
Choose your option
JUBILAB 日本清酒面膜(10片)- 150毫升
Choose your option
JUBILAB 日本米麵膜(10片)- 150毫升
Choose your option
JUBILAB 生長因子維他命C面膜(1片)- 30毫升
Choose your option
JUBILAB 生長因子透明酸面膜(1片)- 30毫升
Choose your option
未來美 修護時空膠囊精華膜 - 80ml
Choose your option
未來美 補水時空膠囊精華膜 - 80ml
Choose your option
未來美 超能膠原B彈力護理修護面膜 - 4片/盒
Choose your option
未來美 超級雙C美白修護生物纖維面膜 - 3片/盒
Choose your option
未來美 超級A醇緊緻透亮面膜 - 3片/盒
Choose your option
未來美 超級A醇緊緻煥白面膜 - 3片/盒
Choose your option
Dr. May 專業級大安瓶修護黑面膜 - 4片/盒
Choose your option
未來美 超保濕胺基酸潔顏乳 - 120ml
Choose your option
未來美 雲朵泡泡潔顏慕絲 - 150ml
Choose your option
Dawn 絲瓜絡天然潔面乳 DL 補充裝 - 280毫升
Choose your option
Dawn 絲瓜絡天然潔面乳 DL - 300毫升
Choose your option
DN 潔面泡沫(Dokudami 潔面泡沫)- 75克
Choose your option
Kirei de Beaute 清新香皂 - 100g
Choose your option
Juliet Ray 潔膚巾(約148張)- 250克
Choose your option
【補水、毛孔、光滑三件套】Arencia 年糕潔面乳隨身小樣組- 3 × 15g
Choose your option
Arencia 綠意清新年糕潔面乳 - 120ml
Choose your option
Arencia 法式金盞花橘年糕潔面乳 - 120g
Choose your option
Arencia 大米珍珠白年糕潔面乳 - 120g
Choose your option
Arencia 皇家玫瑰果粉年糕潔面乳 - 120g
Choose your option

【全效面膜包月組】8分鐘超級面膜 - 4 x 5片
Choose your option

未來美 專業院線PDRN外泌體新生面膜 - 3片/盒
Choose your option

未來美 專業院線PDRN外泌體新生精華 - 15ml + 15ml
Choose your option

未來美 超級雙C美白修護生物纖維面膜 - 3片/盒
Choose your option

未來美 超級A醇精華升級版 - 30ml
Choose your option

未來美 超能膠原B彈力護理修護面膜 - 4片/盒
Choose your option

未來美 超保濕胺基酸潔顏乳 - 120ml
Choose your option

未來美 超級A醇緊緻透亮面膜 - 3片/盒
Choose your option
品牌焦點
韓國專利勝肽+七重玻尿酸,肌膚像「快充」般瞬間滿水,超越傳統保濕 !
未來美 | MIRAE
敷10-15分鐘,一掃疲老黃肌變冷白水光肌!
未來美 | MIRAE
韓國專利胜肽+七重玻尿酸,肌膚像「快充」般瞬間滿水,超越傳統保濕 !
未來美 | MIRAE
含有維他命C與積雪草的生物纖維面膜,有效提亮膚色、增添光澤,減少泛紅。
未來美 | MIRAE
採用專利雙重微囊包覆技術與真空保鮮科技,加速淡化瑕疵並平滑細紋。
未來美 | MIRAE
創新膠原蛋白水光面膜布如「第二層肌膚」般服貼,打造水潤、彈嫩、透亮的光澤!
未來美 | MIRAE
深層補水,每次清潔後都能讓肌膚柔嫩透亮、散發水潤光澤!
未來美 | MIRAE
360°全方位貼合、適配各種臉型,上臉瞬間緊緻,和疲倦、暗沉、老態說再見!
未來美 | MIRAE